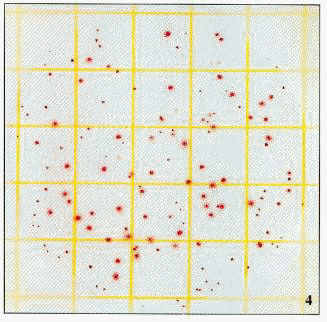

總生菌試紙片(6406)
Aerobic
Count Plate-Petrifilm
(訂購編號6406)
總生菌試紙片(Aerobic Count Plate)
50片/包
總生菌試紙片(Aerobic
Count Plate)是一簡易、快速、準確、專供液體食品使用之總生菌(Aerobic
Count)試紙片。在濾膜上即含有可供培養總生菌的試劑。
並由美國化學物資分析學會(AOAC)認可之試驗方法。
我國食品衛生單位亦認可。
可供測試各種液體食品中的總生菌數,總生菌數傳統上作為一種指示菌,供在水中或其他環境樣品中指示出污染的的程度。
樣品中總生菌數的含量若超過規定的含量,則指示出水源、液體食品受到污染或者在生產過程中的某個階段的衛生條件不合乎衛生標準。
產品附中文使用說明書
Product include Chinese operation manual